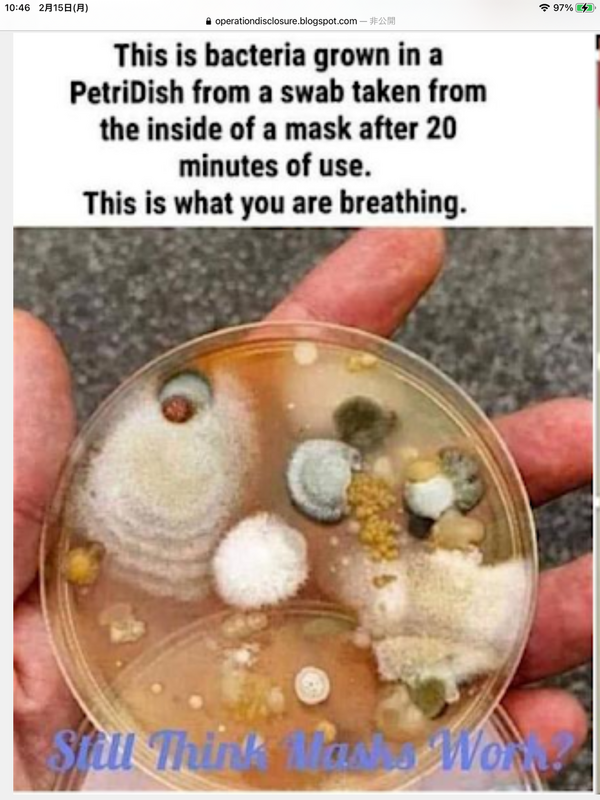

ニュルンベルク・コード(戦争犯罪)
わーー!💦
こんなこと、知らされなければ誰も気づかないでしょう!(゚o゚;;
マスクは外側よりも内側の方が危険なのかも!
皆んな洗脳に気づいて!
転載記事👇
坂本花子
2月16日
以下のマスクの写真を見れば、マスクを日本人に勧める洗脳政策をしている日本政府はコロナウイルス以前からもう何十年にも渡って犯罪を犯しているということですね。日本は昔はガーゼを売るために風邪を引いたときにはマスクをつけるように学校からも、政府、メディアからも洗脳されていたようです。コロナウイルス以前からも、これほどマスクを乱用し、健康に良いと信じ込んでいる民族はあまり見られません。このコロナウイルスで世界中でマスクを売る医療産業やそれに繋がる販売商店だけが儲けています。このためにはテレビ、メディア、商店で一日中数分ごとにマスク着用、社会的距離、消毒とうるさく病的に繰り返し、人々を恐怖に陥れ、今ではマスクを2枚、3枚....まで付けろと言う自称専門家まで現れ、2枚、3枚のマスクを本当に付ける人がみられます。
以下の研究から分かるように風邪などでマスクをつける習慣で肺炎になります。有名なスペイン風邪の時にはマスクで肺炎になり、ワクチンで大量の人々が死んだと言われています。
地方のダイソーでは3D低層的火病の店長が攻撃的な癇癪を起こして、マスクを付けない人に店に入ることを禁じました。フアミリーマートでは熱のある疑いのある人に店への入店を禁じています。これらの店は以下のニュルンベルク・コード(戦争犯罪)によると「人類に対する大罪」です。このような大罪的行動には目をつむらないで、はっきりとさせるべきです。このような店は3Dの低波動の店とも言えます。
ニュルンベルク・コード(戦争犯罪)
開示作戦(Operation Disclosure)| Thinker2
2021年2月14日
私はこれらの画像を使ってチラシを作成し、マスクを義務付けている人々に提示しました。
トランプがオフィスを再開するとき、私は戦争犯罪の起訴のためにそれらを報告します。
ニュルンベルク・コード(戦争犯罪)
第6条:セクション3
いかなる場合でも、労働協約またはコミュニティ・リーダーまたはその他の当局の合意は、個人の告知の基づく同意(インフォームド・コンセント)の代わりにはなりません。
指導者は、国民にマスクを義務付け、彼らが食料や医療にアクセスできないようにすることは戦争犯罪であることを認識しておく必要があります。 マスクまたはその他の医学的介入は、自発的なものでなければなりません。
右の写真は
「貴方がコロナウイルス19ニュースで注意をはぐらかされているうちに以下の社長(CEO)が辞任しています。
「
ディズニー社長辞任
マイクロソフト
・
これは、20分間使用した後、マスクの内側から採取した綿棒からペトリ皿で増殖した細菌です。
これがあなたが呼吸しているものです。
https://operationdisclosure.blogspot.com/2021/02/nuremberg-code-war-crimes.html